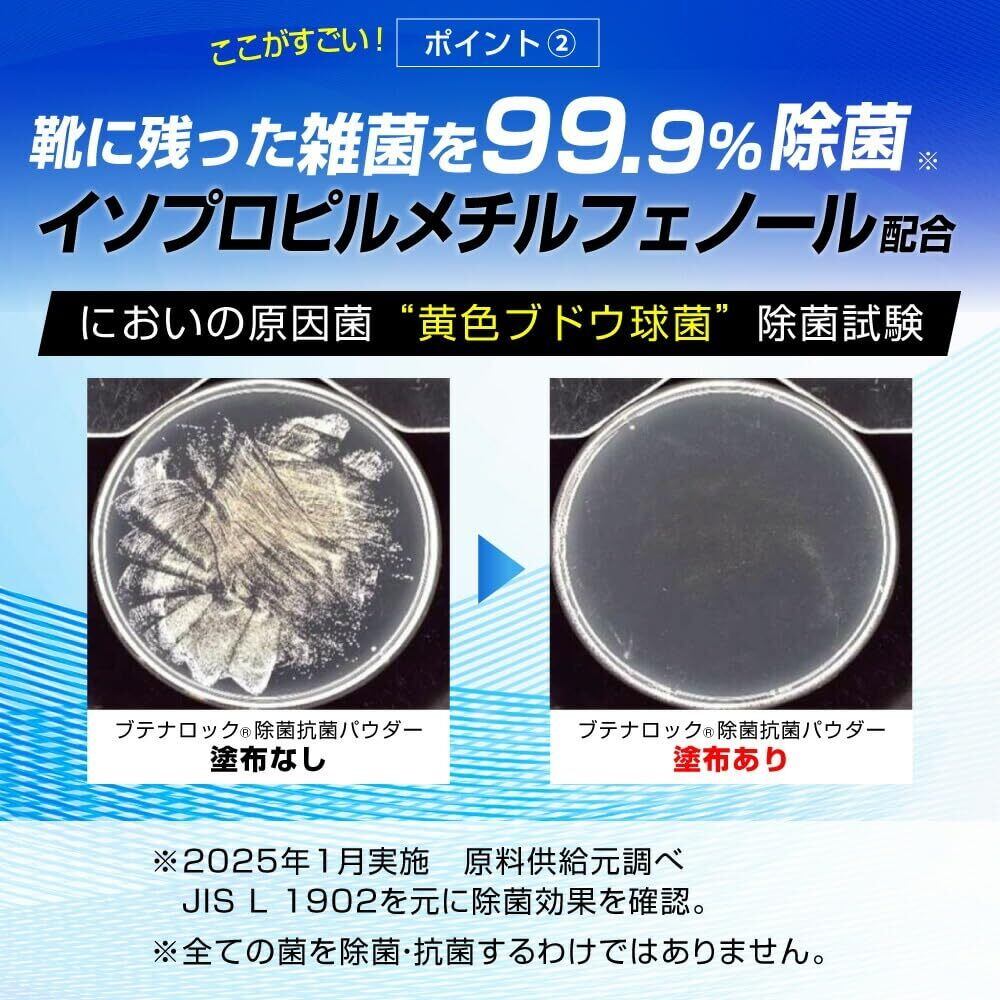

1/9
【在庫処分】ブテナロック 除菌抗菌パウダー 50g 靴強力消臭 99.9%除菌 日本製
¥3,794 税込
残り1点
なら 手数料無料で 月々¥1,260から
この商品は送料無料です。
ご覧いただきありがとうございます。
当店では他サイトにも商品を販売しているため
まれに売れ残りや取り寄せ中となる場合がありますがご了承ください。
【商品名】
ブテナロック 除菌抗菌パウダー 50g 靴強力消臭 99.9%除菌 日本製
【商品説明】
【ご使用方法】 1)靴の中に、片足約1g(小さじ5分の1)ずつ振りかけてください。 2)靴の隅々までいきわたるよう、軽く靴を左右に揺らしてください。 3)そのまま靴を履いてお過ごしください。 ※パウダーは、靴を履いて30分〜1時間程で靴に浸透し、目立たなくなります。
香り ミント, 超強力靴消臭
ブランド ブテナロック
商品の形状 粉末、超強力靴消臭
商品の個数 1
ユニット数 50.0 グラム
メーカー 久光製薬
最後までご確認いただきありがとうございます。
上記をご確認いただき、ご購入いただましたら幸いです。
なにかご不明な点がございましたらお気軽にメッセージからお問い合わせください。
-
レビュー
(21)
-
送料・配送方法について
-
お支払い方法について
最近チェックした商品
セール中の商品
その他の商品